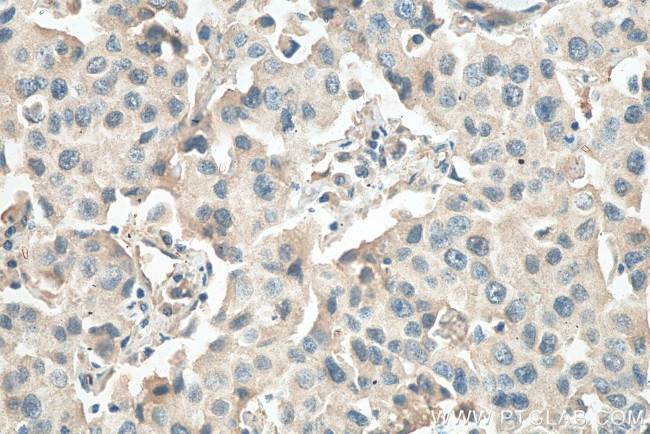
RCHY1 Antibody in Immunohistochemistry (Paraffin) (IHC (P))

Search
Proteintech
RCHY1 Monoclonal Antibody (2C11C11)
{{$productOrderCtrl.translations['antibody.pdp.commerceCard.promotion.promotions']}}
{{$productOrderCtrl.translations['antibody.pdp.commerceCard.promotion.viewpromo']}}
{{$productOrderCtrl.translations['antibody.pdp.commerceCard.promotion.promocode']}}: {{promo.promoCode}} {{promo.promoTitle}} {{promo.promoDescription}}. {{$productOrderCtrl.translations['antibody.pdp.commerceCard.promotion.learnmore']}}
产品信息
67856-1-IG150UL
种属反应
宿主/亚型
分类
类型
克隆号
偶联物
形式
浓度
纯化类型
保存液
内含物
保存条件
运输条件
靶标信息
The protein encoded by this gene has ubiquitin-protein ligase activity. This protein binds with p53 and promotes the ubiquitin-mediated proteosomal degradation of p53. This gene is oncogenic because loss of p53 function contributes directly to malignant tumor development. Transcription of this gene is regulated by p53. Alternative splicing results in multiple transcript variants encoding different isoforms.
仅用于科研。不用于诊断过程。未经明确授权不得转售。
篇参考文献 (0)
生物信息学
蛋白别名: Androgen receptor N-terminal-interacting protein; androgen-receptor N-terminal-interacting protein; CH-rich interacting match with PLAG1; CH-rich-interacting match with PLAG1; DKFZp586C1620; E3 ubiquitin-protein ligase Pirh2; h PRO1996; hPirh2; p53-induced protein with a RING-H2 domain; p53-induced RING-H2 protein; PIRH2E; PIRH2F; ring finger and CHY zinc finger domain containing 1, E3 ubiquitin protein ligase; RING finger and CHY zinc finger domain-containing protein 1; RING finger protein 199; RING-type E3 ubiquitin transferase RCHY1; Zinc finger protein 363; zinc finger, CHY-type
基因别名: ARNIP; CHIMP; PIRH2; PRO1996; RCHY1; RNF199; ZCHY; ZNF363
UniProt ID: (Human) Q96PM5
Entrez Gene ID: (Human) 25898